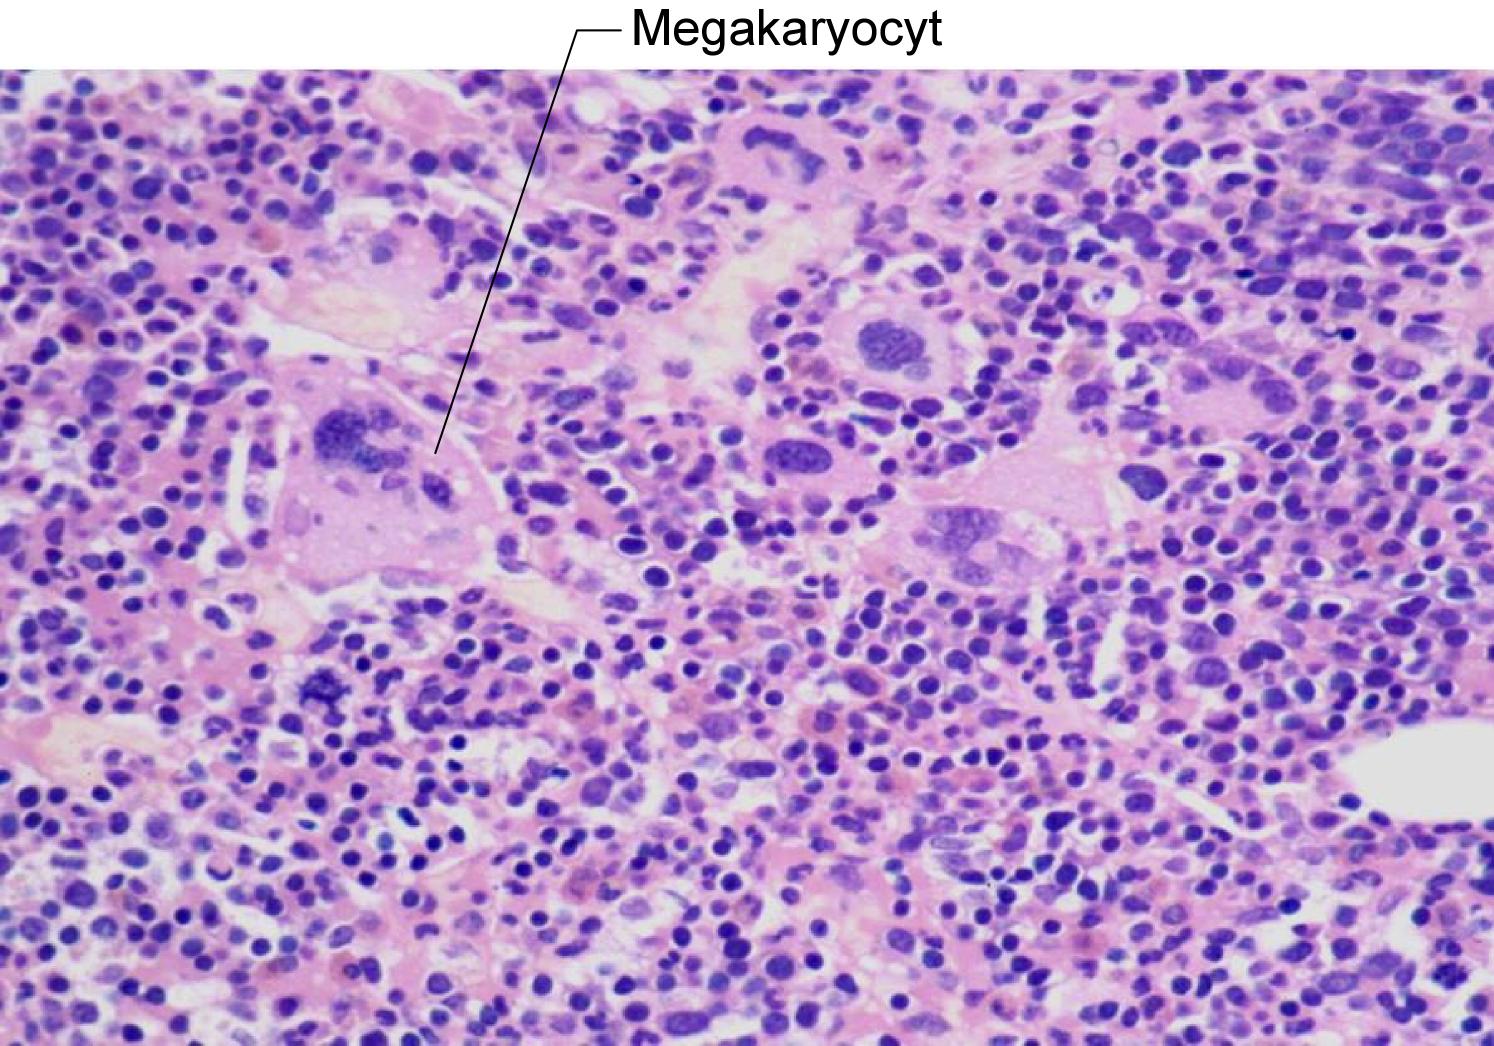
knoglemarvsbiopsi

Knoglemarvsbiopsi -hypercellulær marv med mange megakaryocytter
Vil du vide mere
- Polycythaemia vera - for sundhedsfaglige
- Polycythæmia vera - for borgere
Indhold leveret af
Patienthåndbogen
laegehaandbogen@dadl.dk
Patienthåndbogen
Kristianiagade 12
2100 København Ø
Disclaimer: Patienthåndbogen